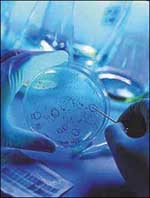

العراق .. بين تغيير الاستراتجية الامريكية وشبح التقسيم | 
* إعداد إسلام السعدني
لا يزال الوضع المتفجر في العراق يفرض نفسه على اهتمامات الصحف العالمية التي باتت تجد في الأزمة العراقية معينا لا ينضب للمقالات والتحليلات التي يسعى كتابها لتلمس طريق للخروج من مستنقع طال أمده في عراق ما بعد صدام حسين.
وفي هذا الإطار ، يندرج مقال (كريسبين بلنت) عضو مجلس العموم البريطاني الذي نشرته صحيفة (الجارديان) البريطانية ، والذي طرح فيه الرجل رؤيته لإعادة الهدوء ........التفاصيل |
|
| بوش وكيري ولعبة الكراسي الموسيقية! | 
* إعداد أشرف البربري
هل يمكن أن يتبادل المرشح الديموقراطي للرئاسة الأمريكية جون كيري والرئيس جورج بوش مقعديهما على صعيد السياسة الخارجية للولايات المتحدة؟ يحاول المحلل السياسي موشيه ناديم تقديم اجابة لهذا التساؤل من خلال تحليل سياسي نشره في مجلة (فورين بوليسي). يشير الكاتب الى ان كوريا الشمالية تفضل المرشح الديموقراطي كيري. فقد أذاع راديو بيونج يانج خطابا كاملا لجون كيري مع تحذيرات من ........التفاصيل |
|
بعد وصول حزبها إلى سدة الحكم في الهند سونيا غاندي.. المرأة الحديدية! | 
* إعداد إسلام السعدني
طرح الفوز المفاجئ الذي حققه حزب المؤتمر بزعامة (سونيا غاندي) في الانتخابات التشريعية الهندية معضلة حقيقية على الساحة السياسية في البلاد في ضوء الأصول الإيطالية لتلك السيدة التي قادت هذا الحزب العتيد إلى تحقيق انتصار كبير أعاده إلى الواجهة مرة أخرى بعد ابتعاد طال عدة سنوات عن سدة الحكم في نيودلهي.
وفي أعقاب ذلك النصر الساحق تناولت كبريات الصحف العالمية هذا الموضوع ........التفاصيل
|
|
بدأته منذ عقود بتنويع مصادر الدخل المملكة دشنت مسيرة الإصلاح الاقتصادي في الخليج | * إعداد هيفاء دربك ورضوان آدم
يشدد الخبراء والمحللون الاقتصاديون على أن المخرج من دائرة عنق الزجاجة التي تمر بها الاقتصاديات الخليجية يكمن في اهتمام الدول الخليجية بالقطاعات الاقتصادية غير النفطية ، وبناء قاعدة إنتاجية تسهم في تنويع موازناتها بمصادر دخل جديدة.
وهو الامر الذي يتفق بقوة وإجراءات الاصلاح الاقتصادي التي أولتها الحكومات الخليجية الاهتمام الأكبر في الفترة الأخيرة.
وفي هذا السياق ........التفاصيل |
|
وصفوها بأنها (أسوأ من أن تكون عديمة الفائدة) ولا تزال تستخدم!! عندما تكذب أجهزة كشف الكذب..! | * إعداد طارق راشد
جهاز كشف الكذب عبارة عن كذاب سيء السمعة. فهذه الأجهزة تورِّط البريء، وتبرئ المذنب. إذن لماذا لا تزال تستخدم من قِبَل وكالات الاستخبارات؟ هل هذا هو الذكاء؟ والشرطة تستخدم أجهزة كشف الكذب في التحريات، لكن النتائج لا يمكن استخدامها بالمحاكم في معظم الحالات.
هل تقوم الشرطة إذن بتضييع وقتها؟ أما المؤسسات، فتستخدم أجهزة كشف الكذب في اختبارات ما قبل التعيين. أو ليس هذا التصرف يجعلهم ........التفاصيل |
|
محيط الأسم عشوائية السمك وتخطيط الحيتان | 
هل يعي صغار المستثمرين ما يحدث في سوق الأسهم؟
أحياناً نظن بأننا مولعون بموضة رأس المال ونبحث عن أسهل الطرق لل (جمع ) وال(تكديس) فكيف يمكن أن تتحول السوق إلى موضة، وبالذات سوق الأسهم.
يحتل العقار مرتبة أولى وسط نهضة عقارية بدأت بمساحات ضيقة ووصلت إلى مخططات مطوّرة ومساهمات بأموال لا تعد ولا تحصى يقف عليها (هوامير) سوق العقار الذين لم يتركوا فرصة لصاحب رأس المال الصغير ليعزز رأسه أو رأس ........التفاصيل |
|
( بين قوسين ) | في هذه الزاوية وبين قوسين يسرنا في منتدى الهاتف أن نضع اقتراحات أصدقاء المنتدى محل اهتمامنا في محاولة لنشر كل المقترحات والآراء التي لا ترتبط ارتباطا مباشرا بموضوع المنتدى.
عبد الكريم العتيبي: أتمنى من جريدة الجزيرة أن تخصص صفحة للقناة الرياضية وأخبارها والمباريات التي تنقلها والدوريات التي تبثها أو تحتكرها.
شهد: أقترح عليكم تناول الإرهاب كمحور للنقاش، ولكم الشكر.
أبو نواف القحطاني: أرجو أن ........التفاصيل |
|
الشاي العلاج الناجع لسرطان البروستات | * إعداد: طارق راشد
توصلت دراسة حديثة إلى أسلوب علاجي سهل ورخيص، ألا وهو شرب الشاي بنوعيه الأخضر والأسود، والذي تشير الدراسات انه قد يكون العلاج الطبيعي المفيد في الوقاية الكيماوية من سرطان البروستات.
ففي دراسة هي الأولى من نوعها، والتي ركزت على دور الشاي في عملية الامتصاص والتأثير المضاد للأورام السرطانية، استطاع باحثون في جامعة كاليفورنيا، بلوس أنجلوس، أن يحددوا وجود مادة البوليفينول ضمن ........التفاصيل |
|
كيف يعمل؟ فيروسات الحاسب الآلي تشابه بينها وبين الفيروسات البيولوجية في تأثيرها وانتقالها | * إعداد سناء عيسى
فيروسات الكمبيوتر أدوات غامضة تجذب انتباهنا وتكشف مدى ضعف أجهزة حاسباتنا، وأي فيروس كمبيوتر معد بإتقان يمكنه أن يؤثر عالمياً على شبكة الإنترنت ويوضح مدى الترابط بين البشر في كل مكان في العالم.
وكان موضوع الدودة (ميدوم) التي أصابت 250 ألف جهاز في يوم واحد من أكثر أنباء الفيروسات شيوعاً، وفي مارس 1999 أجبر فيروس (ميليسيا) شركة مايكروسوفت وشركات أخرى عملاقة على إغلاق أجهزتها ........التفاصيل |
|
يطلقون عليها التأمل في الكون رياضة ال (تاي تشاي) العلاج المنتظر لبعض الأمراض | 
* إعداد سناء عيسى
في عام 1960 أخذت شعبية (تاي تشاي) تنتشر في الولايات المتحدة كعلاج طبيعي وفعال يساعد على الاتزان والمرونة والمشي وأخذ الأوضاع المختلفة والهضم والتركيز وتنشيط الذاكرة والتعافي العام العضوي والعقلي، ويؤكد مؤيدو (تاي تشاي) على تأثيرها الجيد على كبار السن الذين يعانون من أمراض مزمنة.
لكنها تختلف تماماً عن الأنشطة الرياضية مثل الجري وركوب الدراجات والسباحة والمشى مسافات ........التفاصيل |
|
أحدث اختراع طبيب داخل الجسد لمحة على مستقبل الحمض النووي (دي إن أي DNA) |
* إعداد عصمت نجيب
قام العلماء بتطوير ما يقولون انه يمكن أن يصبح أصغر أداة طبية في العالم, وهو حاسب مصنوع من الحمض النووي (DNA) بإمكانه تشخيص المرض ويقوم آلياً بتحديد الدواء لمعالجته.
وهو حاسب متناه في الصغر لدرجة أنه يمكن أن تحتوي قطرة الماء على تريليون نسخة منه, ويتم اختباره وعمله حاليا داخل أنبوبة اختبار، ولن يكون بالإمكان استخدام مثل هذا الجهاز عملياً قبل مضي عقود من الزمان، ولكنه ........التفاصيل
|
|
قصص مأساوية بطلتها (صديقات السوء) فتش عن المرأة.. في فساد المرأة! | 
* القاهرة هيفاء دربك
قديماً قال (إخوان الصفا) ذائعي الصيت في الفلسفة والحكمة:(المرأة تفسد المرأة، كالأفعى تبث السم في الأفعى)!
وإذا انطبقت هذه المقولة على عصر ما فإنها تنطبق تماماً على أيامنا الحالية، حيث تطالعنا الحوادث والحكايات والدراسات الاجتماعية بطوفان من القصص والمآسي، تؤكد صدق قولهم (فتش عن المرأة) ليس في حياة الرجل فحسب، بل في حياة المرأة أيضاً، عندما تلعب حواء دوراً مصيرياً ........التفاصيل |
|
علاقات الأجداد والأحفاد في صلب القانون الفرنسي | 
ينطلق القانون في تأطيره لعلاقة الأجداد بأحفادهم من خلال مبدأ أن الأطفال يحتاجون لتنمية هذه العلاقة مع الجد والجدة من ناحية الأبوين. وليس من حق الوالدين، بدون سبب ظاهر، حرمان الأطفال من هذه العلاقة رغم أنه في بعض الأحيان قد تكون هذه العلاقة بالغة التعقيد.
فالعلاقات بين الأجداد والأحفاد في غاية الأهمية وبناءة لشخصية الطفل، خصوصا عند انفصال الوالدين أوحين يتوفى احدهما..ويكون الطفل تائها وفي ........التفاصيل
|
|
| تحوطات للأمن والسلامة على درجات السلالم | يتعرض المسنون لخطر السقوط على درجات السلالم أكثر من غيرهم ومن الآخرين الذين هم أقل منهم سناً. هؤلاء المسنون قد يعانون خلال تعرضهم للسقوط من إصابات خطيرة بسبب ضعف أجسادهم نسبة لتقدمهم في السن.
وفي الواقع أن المسنين الذين يبلغون من العمر 65 سنة فما فوق ، يشكّلون نسبة 70% من الوفيات التي غالباً ما يكون سببها الرئيسي السقوط على درجات السلالم.
اثنتا عشرة قاعدة ذهبية
لتأمين سلامة المسنين
أولاً: ........التفاصيل |
|
أسبابه...أنواعه...مخاطره...علاجه (1-2) السكَّر... داء الظمأ (Diabetes) | 
إعداد:أ. د. داود جاسم الربيعي(*)
السكر ليس من الأمراض العصرية كما يعتقد ! بل وردت أعراضه في الأدبيات الطبية الصينية القديمة ، التي تعود إلى اكثر من 2000 سنة.
وكان يسمى بمرض الظمأ ، حيث يؤدي إلى العطش الشديد.
وذكروا ان مسبباته هي كثرة تناول الحلوى والدهون واللحوم والوجبات الدسمة، وأكدوا انه كان منتشرا بين الأغنياء، حينذاك.
كما وضعوا له علاجات عشبية وتغذية ، تتمثل في الإكثار من تناول ........التفاصيل
|
|
| فن التطريز.. إبداع يستمد جذوره من التاريخ | 
* إعداد: تنكزار سفوك
يعتبر هذا الفن المميز بأشكاله وألوانه وتقنياته الحديثة والقديمة شاهداً على العصور المتعاقبة، ومرآة عاكسة للحياة اليومية للأجيال، على الرغم من التطور الكبير الذي شهده على أكثر من مستوى سواء على مستوى الألوان المختارة أم على النماذج العصرية والإبداعية الحديثة.
تتم عملية التطريز على السجاد والأثواب والأقمشة غالية الثمن والراقية كالكتان وثوب الحرير أما النقش فيتم على ........التفاصيل |
|
من هنا وهناك | المملكة تفوز بعضوية المجلس الدولي لتنسيق برنامج الإنسان والمحيط الحيوي"ماب"
فازت المملكة بعضوية المجلس الدولي لتنسيق برنامج الإنسان والمحيط الحيوي المعروف ب (ماب) وذلك في الانتخابات التي أجريت أثناء الدورة الثانية والثلاثين للمؤتمر العام للمنظمة الدولية للتربية والعلوم والثقافة (اليونسكو) والذي عُقد في باريس في أكتوبر عام 2003م. يضم المجلس في عضويته 34 دولة؛ وسوف تستمر عضوية المملكة أربع سنوات ........التفاصيل |
|
بمناسبة يوم البيئة العالمي العالم يصرخ: أنقذوا الحياة | |
يصادف السابع عشر من شهر ربيع الآخر 1425ه (الموافق الخامس من يونيو 2004م) الاحتفال السنوي باليوم العالمي للبيئة. وإذا كان قد كثر الحديث فى العقود الأخيرة عن البيئة وقضاياها ومشاكلها، فقدتزايدت كذلك الأصوات العالية التى تحذر من مغبة ما يحدث، وتنادى بالإسراع لإنقاذ البيئة قبل فوات الأوان، رحمة بالبشرية ورغبة فى الإبقاء على سير الحياة. واتخذ كثير من المدافعين عن البيئة والمنادين شعارات بضرورة صداقة ........التفاصيل |
|
مستشارك يجيب | سؤال: قرأت في عدد سابق مصطلح السياحة المستدامة.. فماذا يعني لديكم؟
فهد بن محمد الجديد الرياض
الجواب: السياحة المستدامة تطوير لصناعة السياحة المتعلقة بالطبيعة؛ وتعرف بالسياحة البيئية لأنها تأخذ في الاعتبار عدم الإضرار بأي من مكونات البيئة من نبات وحيوان وظواهر طبيعية جمالية؛ وتتصف بما يلي:
* المحافظة على التنوع الأحيائي والتراث الحضاري للأماكن السياحية.
* الممارسة الحافظة للموقع ضمن طاقته ........التفاصيل |
|
| السوق المفتوح | 
جهاز مبرمج للتدليك الشخصي
Programmable Personal Back Masseuse
السعر: 275 دولاراً
موقع الشراء: www.brookstone.com
* يمكن تحويل أي كرسي الى مسند لجهاز التدليك الفريد هذا.وهذا الجهاز يمنحك ثمانية برامج اختيارية تسمح لك بتدليك الظهر والعنق. وهو يحوي آلية للدحرجة تضمن لك تدليكاً ناعماً بدءًا من أسفل الظهر في المنطقة القطنية الى الأعلى في الرقبة.
ويمكنك جهاز التحكم عن بعد ذو الثلاثة أزرار ........التفاصيل |
|
ملامح عصرية لأحواض المسابح | 
إعداد: تنكزار سفوك
تطورات حديثة طرأت على أشكال أحواض المسابح غيرت ملامح البيئة المحيطة بها، وجعلتها تمتاز بسمات جمالية أساسها التصميم الخارجي الذي يعطي المظهر العام للأحواض والتكوين الداخلي الذي يعكس الجانب العملي والجمالي معاً.
لذا فإن الأمر يتعلق بدراسة مشروع بناء الحوض الذي سيكون مسبحاً للأسرة فالطرائق متعددة والنماذج كثيرة في البناء والتحديث و مواد البناء مختلفة أيضاً.
يتم بناء ........التفاصيل
|
|
| الشرفة الخارجية تتألق بجمال الأرضيات | 
لا شيء يحدد جمال أرضيات الشرفة أكثر من المادة المختارة للقطع التي ستكسو سطحها الخارجي، وهو ما تحددها نوعية الاختيار والذوق والعوامل المادية التي ترسم ملامح الآفاق الجديدة لهذه الشرفات وتعبر عن مدى استفادتها من المنتجات الحديثة.
لذا يتوجب إجراء مقارنة بين الأرضيات الراقية المبنية من قطع الحجر والسيراميك والرخام والمرمر والخشب و بين تلك التي تعد من الإسمنت أو الحجر الرخيص ، واختيار مهندس ........التفاصيل |
|
أثاث الصيف.. نمط جديد لكراسي نموذجية | 
تتسع دائرة التقنيات الحديثة في عالم الديكور والأثاث ليظهر يوماً بعد آخر أثاثٌ يحمل صفات جمالية فيها الكثير من الخروج عن المألوف سواء على مستوى الألوان أو الأشكال والموديلات.
ويبدو أن كراسي هذا الصيف ستحمل ملامح التجديد والابتكار، فالألوان تبدو مختلفة والأشكال أكثر رقياً وتألقاً وتعبر عن فكر إبداعي للمصممين الذين يحرصون على تقديم الجديد باستمرار، تساعدهم في ذلك التقنيات والأجهزة والآلات ........التفاصيل
|
|
| الصيف.. فصل اللعب المرح | 
* بقلم: نادين ديشينو
البرامج الترفيهية التي يجدها الأطفال في فصل الصيف من أهم أسباب السعادة بالنسبة لهم ، حيث انهم يستمتعون بها جيدا ، و يمارسون اللعب دون كلل أو ملل .. أما الكبار فهم سجناء الوقت الضيق و السريع ، سجناء الهموم اليومية ، و الفواتير التي عليهم أن يدفعوا ثمنها باستمرار. سجناء الخوف و عدم اليقين ، وأمام كل هذه التفاصيل الصغيرة ، يجد الكبار أنفسهم خارج متعة اللعب تلك. فاقدين ........التفاصيل |
|
التطور النفسي: حقيقة أم كذب؟ | 
* بقلم: ريتشارد لانجفان طبيب نفساني
عندما يرى أولياء الطفل ضرورة فحص نفسية أبنهم، ويطلبون ذلك باهتمام، يجب على الطبيب النفساني أن يستوعب أولاً ما نوع وما قيمة وما جدوى ذلك الفحص النفسي.
يجب أن تكون له دراية كي يعطي رأيه بكل موضوعية بصفته متخصصا.
يجب أن يدرك ذلك الطبيب أيضا أن رأيه سيكون في غاية الأهمية وانه قد يغير مسار حياته.. وأحيانا يرى الطبيب انه لا بد من فحص نفسية الطفل، رفض أحد ........التفاصيل
|
|
أنت تسألين.. وناهد تجيب إعداد: ناهد أنور(*) | * الأستاذة عالية هاشم مقدمة برامج تسأل: قمت بعمل دورات تدريبية خاصة بالعناية بالبشرة في أوروبا وبعض البلاد العربية فما الفرق بين البيئتين؟
ج من الشجاعة أن نعترف بأن الغرب يتقدم عنا في مجالات كثيرة، ولا بأس من أن نتبادل المعرفة والاطلاع على كل جديد، فالإنسان نسيج واحد في كل بقاع الأرض وما يفيد يعمم وأنا من خلال دورات في أوروبا أتابع كل جديد وحديث كي أكون على اطلاع ومعرفة، اما الدورات في البلاد ........التفاصيل |
|
الجاذبية والجمال! | نتفق جميعاً على حتمية الجمال وأهميته في الحياة، فالنفس تعشقه وتسعد به, ويعد جمال المرأة سيد الجمال في الكون، إذ تملك حواء كماً هائلاً من الأحاسيس والعواطف مع أنوثة غامضة تجعلها تشع جمالاً وبريقا،ً وترفل في عالم حسي يلامس مشاعرها العميقة، لذا فهي تنشد الجمال والأناقة، وتسعى لإبراز جمالها الذي أصبح عاملاً مهما في حياة المرأة العصرية، وأحد رموز نجاحها ودليل ثقتها بنفسها.
الكل يرغب في الجمال، ولكن ........التفاصيل |
|
مريم فخر الدين (حسناء الشاشة) بحسرة: انتهى عصر الرومانسية والجمال!! | 
* لقاء أيمن عبد الحميد
ردود أفعال واسعة النطاق أثارتها الفنانة الكبيرة مريم فخر الدين طيلة الأعوام الثلاثة الماضية بسبب ظهورها المتكرر على القنوات والمحطات الفضائية وقيامها بفتح النار على نجوم ونجمات الزمن الجميل بشكل أثار حفيظة الكثيرين وغضبهم الشديد منها.
مريم فخر الدين الفنانة الكبيرة التي نحتفظ لها في قلوبنا بمكانة خاصة لهذا شعر الكثيرون بحالة من الاستياء الشديد لمشاركتها خلال ........التفاصيل |
|
داليا وأول ماشطح نطح |
ظهرت لنا مذيعة تقول أنها قطرية وعلى قناة قطر.. (داليا) ظهرت مرتين تقدم برنامج ( ليالينا) وهو برنامج فني وللامانة الصحفية فإن فيه جهداً مبذولاً وملموساً واعداداً لايستهان به، لكن (داليا) قتلت هذا الاجتهاد، هي ليست سيئة لكنها لاتحمل الادوات التي تؤهلها لقيادة البرنامج.
الادهى ان حواراتها الصحفية اكثر من عدد حلقات البرنامج وتواجدها اصبح مملاً بل انها تهاجم بعض المذيعات وتوجه لهن الاتهامات وتقلل من ........التفاصيل |
|
| العرفج وخطى الكبار | إعداد: تركي بسام
من الواضح جداً ان المخرج السعودي الشاب فيصل العرفج يسير على خطى كبار المخرجين من حيث الحرفية ودقة العمل.
فيصل الذي يخرج عدداً من البرامج في القناة الرياضية يمتاز بأن بصمته معروفة وواضحة وبمجرد متابعتك لأي برنامج يقوم باخراجه فانك تعرف تماماً ان فيصل هو الذي يقود الكاميرا من خلفه. هؤلاء شباب سعوديون اتيحت لهم الفرصة لكي يظهروا ابداعهم فاثبتوا جدارتهم وقدرتهم مع العلم انهم يتلقون ........التفاصيل |
|
مرة أخرى تلفزيون الواقع |
مازالت القنوات الفضائية اللبنانية تصر على تقديم مايسمى بتلفزيون الواقع بعد الضجة الكبيرة التي احدثها برنامج (ستار اكاديمي) و(سوبر ستار) الا ان هذه المرة فاجعة كبيرة فقد تم ترشيح 16 فتاة لمسابقة ملكة جمال لبنان وفرت لهن قناة خاصة وبث متواصل خلال الـ 24 ساعة وكل اسبوع تخرج واحدة من التنافس وعلى المشاهدين التصويت بعد متابعة البث الحي لحياة المرشحات، وهذا حديث فيه كثير من العجب بالرغم من ان التنافس ........التفاصيل |
|
| يوميات ريتا تحتاج إلى إعداد أكثر | |
بعد النجاح الذي حققته المذيعة والاعلامية اللبنانية ريتا خوري اكدت مقدرتها على التواصل عبر برنامجها اليومي على قناة المستقبل (يوميات) وهو من البرامج الجيدة في الفضائيات العربية والتي تستحق المتابعة والمشاهدة الا اننا نجده كونه يوميا يشكل عبئا على الجمهور المشاهد حيث من الصعب على الانسان أن يجلس يومياً في نفس الوقت ليتابع البرنامج وهذا الاستهلاك اليومي أثر بشكل كبير على اعداد البرنامج حيث اخذ يضعف ........التفاصيل |
|
مشاعل الزنكوي: من تعتمد على جمالها ستلتزم بيتها يوماً ما | 
مشاعل الزنكوي مذيعة متميزة جداً في تلفزيون الكويت.. حاصلة على بكالوريوس الاقتصاد والعلوم السياسية من جامعة الكويت بتفوق، التحقت بالتلفزيون بعد ان اجتازت دورة القاء في المعهد العام للفنون المسرحية وكان ترتيبها الاولى على الدفعة وقد نجحت مشاعل بملامحها شديدة البراءة في ان تعكس قلوب الناس واكدت ذلك من خلال ما قدمته من برامج لاقت القبول والاستحسان.
* كيف بدأت حكايتك مع الاعلام؟
حكايتي مع ........التفاصيل
|
|
| ................أخبار سات................ | * قررت ادارة قناة الجزيرة الرياضية اقامة 41 شاشة عرض كبيرة على نفقتها الخاصة يتم وضعها في عدد من المدن والاحياء المصرية والمقاهي الشعبية والفنادق والمناطق السياحية الهامة ليتسنى للجميع نقل احداث مباريات كأس الامم الاوروبية لكرة القدم 2004 على الهواء مباشرة.
* تبث art قناة جديدة خاصة بالمناسبات وهي احدث القنوات التي انطلقت اخيراً من شبكة راديو وتلفزيون العرب art وهي تهم الافراد والشركات والجامعات ........التفاصيل |
|
داود حسين على أوربت | في برنامجه الشهير «داود شو» انتهى الفنان الكويتي «داود حسين» من تصوير حلقات جديدة، حيث يقوم بدور مذيع يستضيف مجموعة من الشخصيات الفنية والإعلامية والرياضية.. ويناقش معهم عدداً من القضايا الساخنة في المنطقة العربية.
البرنامج يكتبه قاسم عبد القادر ويخرجه أحمد الدوغجي وسوف تبث حلقاته على قناة «فن» الجديدة بمجموعة أوربت.
داود قال إن الحلقات الجديدة حافلة بالمفاجآت وإن المشاهدين سوف يرون ضيوف ........التفاصيل |
|
| يمنى شري مطربة.. أخيراً | | بعد ان فرضت نفسها على الاعلام والاعلاميين وحينما ضاقت بها ساحات الاعلام، وواجهتها جملة من التحديات اتجهت نحو الغناء وهي الآن تعد العدة لاصدار البومها الاول وتجري التدريبات الموسيقية وهذا التحول السريع من الاعلام الى الغناء لا يؤكد غير انها وغيرها من الاعلاميات الدخيلات على الاعلام لايمكن ان يثبتن وجودهن في الاعلام العربي مهما فعلن لذا نجد الكثير من المذيعات ومقدمات البرامج يظهرن في كثير من ........التفاصيل |
|
ذكريات.. سميحة أيوب |
أصدرت الفنانة سميحة أيوب كتاباً بعنوان (ذكرياتي) استهل الكتاب بمقدمة للدكتور سمير سرحان ثم مقدمة أخرى للكاتبة سناء البيسي التي اختارت عنوان ( الشامخة دوماً) ثم مقدمة أخيرة لرجاء النقاش بعنوان (فنانة تألمت ثم أبدعت) وقال انه من أصعب الأمور ان نتحدث عن شخصية عامة أجمع الناس على محبتها وتقديرها.........التفاصيل |
|
| * أخبار سريعة * | * انضمت دنيا سمير غانم الى قائمة الممثلات المطربات حيث تقوم حالياً بتجهيز اول البوم لها مع مجموعة كبيرة من الملحنين والمؤلفين منهم رياض الهمشري ووليد سعد وهاني عبدالكريم والالبوم من انتاج نصر محروس.
* بعد اطلالتها التلفزيونية في ستار اكاديمي صورت باسكال مشعلاني حلقة في برانامج (ساعة بقرب الحبيب) وتستعد لتصوير اغنية (مش عارفة انساك) وهي من اخراج محمد المهدي.
* سافر محمد هنيدي لتكملة تصوير فيلمه ........التفاصيل |
|
اللهجة البيضاء.. هل تنقذ الفنانين من أزمة اختلاف اللهجات؟! | اتجه كثير من الفنانين العرب إلى اللهجة البيضاء وهي الاقرب الى العربية الفصيحة في تقديم اعمالهم في محاولة منهم للوصول الى كافة ارجاء الوطن العربي من مشرقة الى مغربة وهذه بادرة طيبة في ان يجد الفنان اياً كانت جنسيته او منطقته ان اعماله تتداول في كافة البلدان العربية فقد اتجه الفنان العراقي كاظم الساهر منذ وقت طويل للغناء باللغة العربية الفصحى ووجد قبولاً كبيراً في الوطن العربي واستطاع ان يخرج من ........التفاصيل |
|
| إلين خلف تفكر في التمثيل | | تستعد إلين خلف لإصدار البومها الجديد، وهي في القاهرة لمتابعة التحضير لهذا الالبوم الذي تعاملت فيه مع أشرف سالم ووليد سعد وشادي إبراهيم وجورج مردوسيان. ومن ناحية أخرى مازالت إلين تدرس العرض الذي تلقته من المخرج عادل الأعصر لتمثيل فيلم سينمائي مع الممثل الشاب أحمد عز، ولم تتخذ قرارها النهائي بالموافقة أو الرفض حتى الآن.........التفاصيل |
|
أحمد رزق يصور في أوغندا |
الفنان الشاب أحمد رزق يطير قريباً الى كينيا واوغندا لتصوير بعض مشاهد فيلمه الجديد (احفاد طرزان) ويدور الفيلم في اطار كوميدي حول مجموعة من الشباب يسافرون الى احدى الدول الافريقية ويتعرضون لعدة مواقف ضاحكة هناك.........التفاصيل |
|
| سيناريو | | * ذهب النجم الخليجي الشاب للقاء مدير احدى الوكالات الاعلانية ليتفق معه على تفاصيل الحملة الاعلانية التي رسمتها الوكالة لتقديمها واثناء الحوار فوجئ المدير بالنجم يطلب مليون ريال مقابل الحملة فكاد الرجل يصعق وقال له بصراحة انه ليس من نجوم الصف الاول لكي يطلب هذا المبلغ الضخم وانه كان قد خصص له 150 الف ريال ولكن النجم رفض العرض وغادر المكتب غاضباً فاتصل المدير بنجم آخر من جيله واتفق معه على مائة الف ........التفاصيل |
|
أغنية «إنت تأمر» | * كلمات: الشاعر محمد القرني
* الحان وغناء: أصيل أبو بكر
هذا الشبل من ذاك الأسد.. الفنان الشاب المتألق أصيل أبو بكر نشأ وتربى في بيت الطرب الأصيل فكان فنانا مرهف الحس منذ نعومة أظافره وهو الذي تشرب أسس الفن من والده الفنان الكبير أبو بكر سالم في هذا العمل يلتقي مع الشاعر الكبير محمد القرني في أغنية ( إنت تأمر) والتي لحنها بنفسه فكانت إحدى روائع الطرب الحديث.
* كلمات الأغنية:
إنت تأمر غالي ........التفاصيل |
|
جوليا بطرس: روح المقاومة لم تبعدني عن الأغنية العاطفية |
تحمل في صوتها روح المقاومة وأهازيج الفرح وتخبئ في كلماتها عناوين الغد ظهرت جوليا بطرس في ألبومها الأخير ( لا بأحلامك) تحاسب فيه الصمت العربي المطبق، وتلوذ أبداً في ثوب زياد بطرس ونبيل أبو عبده.
توارت واختفت في السنوات الماضية لتمنح أمومتها حقها مع سامر وطارق وهي الفنانه التي أثارت وألهمت مشاعر العرب من المحيط إلى الخليج نلتقيها في هذه المساحة لنقرأ تفكيرها وتطلعاتها.
* ألبومك الجديد ( لا ........التفاصيل |
|
أشهر عشرة أفلام في شباك التذاكر الأمريكي هذا الأسبوع |
(10) Super Size Me (اعطني الحجم الكبير)
(وثائقي) بهذا الفيلم أراد مورغان اسبورلوك توثيق فترة شهر من حياته لن يتناول خلالها سوى وجبات من سلسلة مطاعم ماكدونالدز، وكان عليه أن يتناول جميع الأصناف الموجودة على قائمة الطعام ولو لمرة واحدة على الأقل، كما عليه أن يختار دائماً الحجم الكبير من الأصناف إذا كان يوجد بالطلب ذلك الخيار .
(9) Kill Bill Vol. 2 «اقتل بيل الجزء الثاني »
(آكشن / مغامرات) ........التفاصيل |
|
جوائز مهرجان «كان» السينمائي الدولي النصيب الأوفر لمخرجي آسيا.. والكلاب كانت الأفضل!! | 
إعداد: نورين جبريل
فاز فيلم الوثائقي (فهرنهايت 11 9) للمخرج السينمائي الأمريكي مايكل مور بجائزة السعفة الذهبية لمهرجان كان السينمائي الدولي. وحظي الفيلم الذي ينتقد سياسات الرئيس الأمريكي جورج بوش بإعجاب لجنة التحكيم في ليلة سيطرت عليها أفلام الطابع السياسي، حيث رافق فيلم مور في المهرجان فيلم آخر للمخرج البرازيلي والتر ساليس بعنوان (يوميات الدراجة النارية) الذي تناول قصة حياة الثائر ........التفاصيل |
|
وضع لها تصوراً جديداً وحصل على تأييد بروسنان.. نجاحات ترانتينو تغريه بإخراج سلسلة جيمس بوند |
أعرب المخرج السينمائي الشهير كوينتين ترانتينو عن أمله في إضفاء أسلوبه الفريد على الفيلم الجديد من سلسلة أفلام جيمس بوند الشهيرة الذي سيقوم بإخراجه بعد النجاح الذي حققه فيلمه الأخير (اقتل بيل). وظل تراتنينو طيلة حياته من المعجبين بالملحمة السينمائية لعميل الاستخبارات البريطانية جيمس بوند الذي يجسد شخصيته حالياً الممثل الايرلندي بيرس بروسنان، ولكنه يشعر أنه من الممكن إدخال بعض التحديث على سلسلة ........التفاصيل |
|
| حظر عرض الأفلام الأجنبية في الصين |
في خطوة تهدف إلى دعم ومساندة الأفلام المحلية وصناعة السينما في الصين، أصدرت السلطات الصينية المعنية قراراً يسري مفعوله مباشرة بحظر عرض الأفلام المستوردة ولا سيما القنبلتين السينمائيتين فيلم (هاري بوتر وسجين أزكابان) وفيلم (الرجل العنكبوت الجزء الثاني) في دور العرض السينمائي بالصين.
ونقلت الصحف الصينية عن مسؤولين قولهم إنه يمكن لدور السينما فقط عرض الأفلام السينمائية المحلية وتلك التي تعرض في ........التفاصيل |
|
الفيلم الأمريكي (فهرنهايت 11/9) للمخرج مايكل مور منع في أمريكا.. وفاز بجائزة كبرى في فرنسا | 
* باريس هند حيدر
أثار فيلم مايكل مور الوثائقي الأخير الحائز على السعفة الذهبية من مهرجان كان السينمائي عاصفة من النقد والتساؤلات ما بين مؤيد ومعارض لمنهج مايكل مور في انتقاد المجتمع الأمريكي والسياسة الأمريكية ممثلة في الرئيس بوش ومسألة احتلال العراق.
ورغم أن البيت الأبيض وصفه بأنه مضلل بشكل سافر، إلا أن الفيلم الذي وجّه نقدا لاذعا للرئيس الأمريكي قوبل بحماس كبيرفي هوليوود.
فلماذا كل ........التفاصيل
|
|
جيمي هاسيلبانك المطرقة السمراء | 
إعداد : خالد الطياش
هداف نادي تشيلسي الإنجليزي، المهاجم الأسمر الخطير جيمي هاسيلبانك يتميز بالأهداف الصاروخية الرائعة، ويمتلك قدماً قوية لا تخطئ المرمى وحساً تهديفياً عالياً، وترجع أصوله لجزيرة سورينام المستعمرة الهولندية وبدأ في الدوري الهولندي وتألق في الدوري البرتغالي واشتهر في الليجا الإسبانية ليصبح أحد أهم نجوم الدوري الإنجليزي الممتاز، ويعتبره المدربون المهاجم المثالي في خط الهجوم ........التفاصيل |
|
متفرقات رياضية سريعة | * جدد لاعب وسط بولتون النيجري جاي جاي أوكوتشا عقده مع الفريق لثلاث مواسم أخرى.
***
* انتقل مدافع روما جوناثان زبينا الى فريق اليوفنتوس ووقع على عقد لمدة خمس سنوات.
***
* انتقل لاعب وسط ولفرهامبتون إليك راو إلى صفوف رانجرز الاسكتلندي لمدة عامين، والانتقال جاء حراً بسبب سقوط فريق وولف إلى الدرجة الأولى.
***
* انتقل الأرجنتيني والتر صامويل من روما الإيطالي إلى ريال مدريد الأسباني, وسيتقاضى ........التفاصيل |
|
| خروج الألماني مايكل شوماخر والإيطالي تروللي يحقق فوزه الأول في سباقات فورميولا وان | |
حقق الإيطالي يارنو تروللي فوزه الأول في تاريخ سباقات الجائزة الكبرى لسيارات الفئة الأولى (فورميولا وان) عندما حسم سباق موناكو لصالحه بعد منافسة قوية مع البريطاني جنسن باتون سائق بار هوندا، وقطع تروللي السباق في زمن قدره ساعة و45 دقيقة و46.601 ثانية. وجاء باتون في المركز الثاني بفارق 497 على الألف من الثانية, فى حين حل البرازيلي روبنز باريكيللو سائق فيراري في المركز الثالث بفارق دقيقة و15.766 ........التفاصيل |
|
كاماتشو مدرب الريال الجديد سأجعل الفريق في صدارة إسبانيا والعالم |
تعاقد نادي ريال مدريد الاسباني مع المدرب الاسباني خوزيه أنطونيو كاماتشو بعد 24 ساعة فقط من إقالته المدرب البرتغالي كارلوس كيروش. وكان أول تصريح أدلى به كاماتشو يقضي بأن هدفه الأساسي هو إعادة الفريق لوضعه الطبيعي كأحسن فريق في اسبانيا والعالم, نافياً أن يكون سبب حضوره هو إرساء قواعد الانضباط بين اللاعبين. ونقلت صحيفة ماركا الاسبانية عن كاماتشو قوله في مؤتمر صحفي: (لاعبو ريال مدريد غير متخاذلين ........التفاصيل |
|
| ديفيد بيكهام يطالب بالكف عن تناول سيرته الخاصة | | فجر قائد إنجلترا ديفيد بيكهام غضبه الشديد في وجه الصحافة والإعلامالإنجليزي لمواصلتهم الحديث عن فضيحته وعلاقاته العاطفية مؤخراً مع مساعدته الشخصية في اسبانيا, وقال بيكهام خلال تواجده في معسكر تدريب في ساردنيا مع منتخب بلاده عبر راديو البي بي سي بأنه يجب التوقف عن الحديث في تلك الأمور، وبأنه رجل متزوج ولديه طفلان، ويحاول التركيز للدخول في مهمة وطنية لمصلحة منتخب بلاده. وأضاف أن تلك الادعاءات ........التفاصيل |
|
الاتحاد الأسكتلندي يوقع عقداً مع قنوات سيتانتا لبث مباريات الدوري الممتاز | وقع مسؤولو الاتحاد الاسكتلندي عقداً مع قنوات سيتانتا للتلفزة لمدة 4 سنوات متتالية لبث 38 لقاءً ضمن فعاليات الدوري الاسكتلندي الممتاز. وقال مدير تطوير التلفزة والتسويق روجر هول: إن التغطية ستتركز على مباريات أكبر الفرق من حيث الشعبية، وهما سيلتك بطل الدوري والكأس ورينجرز العريق. وتابع حديثه بأن تركيزهم سيكون على مباريات أكبر الفرق من حيث عدد الأنصار والمشجعين لبث الحماس والإثارة وجذب اهتماماتهم ........التفاصيل |
|
رؤية متى تعود مسابقة المقالة؟ | |
مسابقة المقالة توقفت منذ سنتين فمتى تنطلق؟ يقدم الطلبة في مادة الإنشاء المقالة بأنواعها فمتى نرى ما يقدمونه في حصتهم في مسابقة عامة وفي صفحات ومجلات خاصة بها وبهم؟ المعروف أن مجلات الوزارة وخاصة (الأجيال)، (وعارف) تحتضن مثل هذه المقالات ولكن غزارة المطروح تقتضي أن تنطلق مسابقة المقالة وحدها، نتمنى من المعلمين أن لا يبخلوا على طلابهم المتميزين في كتابة المقالة وتطبيق أسس التحقيق وأن يرسلوا لنا ........التفاصيل |
|
تحقيق النشاط الطلابي بعيون المشاركين فيه: | * استطلاع يحيى الحربي
كان محور اهتمامنا في استطلاع هذا الأسبوع يدور حول مدى قناعة الطلاب بالنشاط الطلابي والذي يتم ترجمته بالانضمام لجماعات النشاط، وقد توجهنا بسؤال إلى جميع المشاركين من الطلاب حول أسباب انضمامهم.. وكانت الحصيلة كما يلي:
يقول الطالب سطام بن عبد الرحمن الشهري إنه ملتحق بالفعل بإحدى جماعات النشاط الطلابي، ويشير على أنه التحق بالجماعة التي اختارها بعد أن سمع عنها الكثير من الحديث ........التفاصيل |
|
| تصريف السيول في المدارس وحولها | 
مشكلة تصريف السيول في بعض المدارس قائمة وبحاجة إلى حل سريع لكي لا يتعرض أبناؤنا الطلاب لأي مشكلة من أي نوع ولكي تبقى المدرسة جميلة وبعيدة عن أوبئة المستنقعات.. فمن يساعد المدارس في تخطي مشكلة التصريف خاصة في الملاعب الترابية والأفنية الصلبة؟.........التفاصيل |
|
نجوم الميدان | اسم الطالب: عبد الله بن مسفر بن عبد الله الشهراني
العمر: 17 سنة
المرحلة الدراسية: الصف الثاني الثانوي شرعي
المدرسة: ثانوية الشوكاني الرياض
الموهبة : العمل الصحفي
المشاركات:
1 تحرير استراحة مجلة السمو الصادرة بالكويت.
2 تحرير مجلات صحفية مدرسية.
3 مقالات متنوعة بالصحف المحلية.
4 استراحة مجلة الأجيال الصادرة عن وزارة التربية والتعليم.........التفاصيل |
|
| من رسومات طلابنا الأعزاء | 
* تغطية: المعلم صالح الدوسري
الطالب عبد العزيز بن إبراهيم المطوع من ابتدائية الحارث بن ابراهيم أرسل لنا أصل أحد رسوماته لهذا العام 1425هـ ونحن بدورنا نعرض هذه الموهبة التي نتمنى أن تأخذ طريقها نحو الإبداع وشعارنا هنا التحفيز والتشجيع للأجيال الواعدة.........التفاصيل |
|
|
شجون تربوية روح بلا جسد عبدالرحمن بن ناصر الحزاب (*) | منذ أن كنت شاباً يافعاً في المرحلة الثانوية كانت لدي طموحات وأمنيات، فكنت أستطيع ان أحقق البعض منها من خلال تلك المناشط التربوية وبعض الإمكانات التي هيئت من أجلنا. وأصبحت تلك الذكريات الجميلة تتوارد على ذهني وتكبر مع مرور الزمن لا لشيء ولكن لأثرها في نفسي ولأرد الجميل وتلك الخبرات التربوية التي استقيناها من ذلك النبع الذي لا ينضب.
وبحمد الله أصبحت معلماً تربوياً أحمل هم أبنائنا الطلاب بعدما كان ........التفاصيل |
|
موهبة معلم | الأستاذ سعيد بن سلمان العمري المعلم في ابتدائية علي بن ابي طالب بمدينة الرياض يبدع في تصوير وضع المعلمين مع نصاب الحصص. ويعد المعلم سعيد من خيرة المعلمين ومن الموهوبين والمشاركين في المعارض الفنية المقامة في بلادنا الغالية، وقد أرسل لنا عدداً من الرسوم الكاريكاتورية، وتواصلاً مع التربويين اخترنا هذه الرسمة المعبرة، وشعارنا دائماً نحو الإبداع والتشجيع وإبراز مواهب وإبداعات العاملين في الميدان ........التفاصيل |
|
تقرير نشاط من القصائد الوطنية في مدارسنا | | القصيدة التي بين أيدينا ألقاها الطالب يزيد بن حمد الجبرين من مدارس عهد الأهلية بمدينة الرياض كمشاركة في مسابقة فرسان الإلقاء التي تقدم مهارات الطلاب في الإلقاء والتعبير بإشراف القسم الثقافي في النشاط الطلابي بالإدارة العامة للتربية والتعليم بالرياض. وقد حصل الطالب يزيد على المركز الأول في إلقاء الشعر وتم تكريمه في مهرجان الإلقاء والتعبير الذي أقامته الإدارة العامة بالرياض. وهذه القصيدة قدمها ........التفاصيل |
|
نكات تربوية |
* يقال :إن أحد المعلمين كان متوعكاً، وجلس ينجز بعض أعماله داخل الفصل حيث يستعرض دفاتر طلابه وكل ما أنجز دفترا قال لصاحبه من الطلاب (يعطيك العافية) ويرد الطالب (الله يعافيك) فقال أحد الطلاب أنت تقول لهم كلمة (يعطيك العافية) علشان يدعون لك بالشفاء... فضحك المعلم من نباهة الطالب!!
* ويقال: إن خمسة معلمين تحمسوا للحفل الختامي في المدرسة فأعدوا مسرحيات ومشاهد أخذت وقتاً طويلاً لعرضها من الساعة ........التفاصيل |
|
| الرياضيون مع ذوي الاحتياجات الخاصة | ذوو الاحتياجات الخاصة في صورة جماعية أثناء إحدى الزيارات التي تقوم بها مدارس التعليم العام في الرياض ويظهر في الصورة اللاعبون الدوليون محمد شليه، عبدالله الواكد، نواف التمياط، عبدالله سليمان مع طلاب مدرسة أسعد بن زرارة الابتدائية.
هذه الصورة التذكارية ضمن زيارة لمعسكر المنتخب السعودي في ملعب الأمير فيصل بن فهد.........التفاصيل |
|
حيوان اجتماعي أصله بري سبع البحر.. الوحش الظريف! | 
* إعداد ولاء حمادة
سباع البحر حيوانات اجتماعية تعيش في مستعمرات تضم الآلاف من الذكور والإناث، وهي واحدة من الحيوانات الثديية القليلة التي هجرت البر لتعيش في البحر، فأصبح شكلها يشبه الأسماك في انسيابيته، لكنها من آكلات اللحوم شديدة المراس، ورغم مظهرها الضخم المخيف فهي كائنات وديعة مسالمة، تقضى معظم حياتها على الشواطئ فيصطادها البشر طمعاً في دهونها، وعندما تنزل الماء تتربص بها أسماك القرش ........التفاصيل
|
|
| أنت تسأل والخبير يجيب | * كيف نضع الفيل في الحظيرة بثلاث حركات؟
1 نفتح الحظيرة.
2 نضع الفيل فيها.
3 نغلق باب الحظيرة.
* كيف نضع الزرافة في الحظيرة بأربع حركات؟
1 نفتح الحظيرة.
2 نخرج الفيل منها.
3 نضع الزرافة فيها.
4 نغلق الباب.
* في الحفلة التي أقامها الحيوانات كان هناك حيوان غائب، فمن هو؟
إنها الزرافة، فهي موجودة في الحظيرة!!
* كيف تختبئ الزرافة في حقل الفريز؟
تلون أظافرها بالأحمر.
* ما هو الفرق بين ........التفاصيل |
|
حكم وأشياء أخرى | في إحدى المباريات الحاسمة بين فريق من الفئران وفريق من الفيلة، كانت نتيجة المباراة في صالح فريق الفيلة، فقال كابتن الفريق:
نحن متأسفون جداً، إذا كنا قد سحقنا عددا من لاعبيكم.
فرد عليه كابتن الفريق الآخر:
لا بأس يا صديقي، فنحن أيضاً مارسنا القسوة في لعبنا.
&&&
قال الرجل لصاحبه:
هل تعلم أن كلبك يتثاءب كثيراً في المساء!
نعم، لأنه ينام طوال النهار!!
جدل إشارات.. نتجه إلى اليسار أم لا؟!!........التفاصيل |
|
| قصص ولكن | المهم في الحياة
في أحد الأيام طلب من بروفيسور طاعن في السن خبير ومحاضر كبير في القضايا الإدارية أن يلقي محاضرة على فريق من الإداريين والمسؤولين في إحدى الشركات الكبيرة في البلاد، حول (أفضل استغلال للزمن) وحددوا له مدة المحاضرة بساعة فقط.
بدأ المدرس العجوز بإلقاء محاضرته: (سوف نقوم بتجربة) أخرج المدرس إناءً كبيراً من تحت الطاولة، يسع 4 لترات تقريباً، ثم أخرج 12حصاة كبيرة من تحت الطاولة، وقام ........التفاصيل |
|
|
| هندي يبحث عن الزوجة المائة! | يبحث الهندي أودايناث داكشينيري من مدينة أورالي في مقاطعة أوريسا الهندية عن عشر زوجات أخريات ليتم بهن المائة زوجة، بعد زواجه من 90 امرأة في حياته التي امتدت حتى 80 عاماً حتى الآن.
ويقول أودايناث أنه قد تلقى 9 عروض حديثة للزواج من نساء من عدة دول حول العالم، فلديه 3 عروض من كل من الولايات المتحدة واليابان، وعرضان من المجر وآخر من ألمانيا.
وقد ولد أودايناث لعائلة غنية من أصحاب الأراضي الزراعية، ........التفاصيل |
|
جاء يكحلها..! | تسبب سائق ألماني في وقوع أضرار وتلفيات بمحطة وقود بلغت قيمتها 5 آلاف دولار وذلك أثناء محاولته استخدام المكنسة الكهربائية في شفط وقود من داخل سيارته.
وكان السائق قد قام بملء سيارته بالوقود من خزان الجاز بدلاً من البنزين، وطلب مساعدة عامل المحطة الذي ساعده في نزح الوقود من داخل سيارته، ولكن إمعانًا في الاحتياط قام السائق باستخدام مكنسة كهربائية لنزح بقية الوقود الخطأ من داخل خزان سيارته.
وأوردت ........التفاصيل |
|
وهكذا دواليك منقا عبدالباسط شاطرابي |
والمنقا نجدها مكتوبة احياناً ( مانجو) أو ( مانغو).. ويبدو ان الاسم أخذ من الاعاجم فصار أصلاً في حين أننا لو أردنا نسبتها الى بني يعرب والسودانيون منهم فهي ( منقا) حسبما ينطقها الأزوال.
والسودانيون يجب ان يكونوا مرجعاً في نطق كلمة منقا لانهم الأكثر انتاجاً لهذه الفاكهة على مستوى العالم العربي، وهذا يعني أنهم الأكثر معرفة بها ومن ثم الأقرب الى نطق مسماها بالشكل الصحيح.
تصوروا أن المنقا التي تلهب ........التفاصيل |
|
ملجأ القطط! | 
مجموعة من القطط تملأ إحدى الغرف في ملجأ للحيوانات بمدينة سانت بطرسبرج في روسيا الاتحادية. ويعيش في هذا الملجأ حوالي 400 حيوان لم تجد من يعتني بها. (رويترز)........التفاصيل
|
|
يشهدها العالم عام 2020 حشرات آلية.. بطلة الحروب القادمة!! | 
* اعداد ولاء حمادة
قوبلت كل الاختراعات والاكتشافات في العالم بالدهشة أحياناً، وعدم التصديق في بعض الأحيان لأن الإنسان العادي قد يصعب عليه تخيلها في بادئ الأمر لكن سرعان ما تصبح حقيقة وواقعاً ملموساً.
والأحدث الآن والذي يعكف العلماء على انجازه هو الحشرات الآلية (المقاتلة) التي ستقود حروب العالم عام 2020 وهي حشرات لا يتجاوز حجمها حجم الدبوس الذي يمكن حمله على طرف الإصبع.. يقول أحد علماء ........التفاصيل |
|